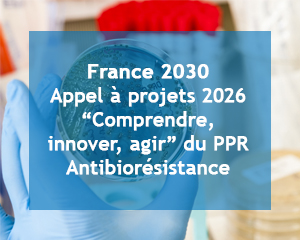
AAP PPR Antibiorésistance

La newsletter PROMISE n°50 du mois de mars 2026 est parue

La dernière édition de la lettre d’actualités PROMISE est en ligne. Cette newsletter n°50 du mois de mars 2026 vous propose les dernières actualités relatives à l’antibiorésistance et à l’approche globale One Health, dans une perspective de diffusion d’informations. Au programme notamment : Si vous souhaitez vous abonner (ou vous désabonner), rendez-vous en bas de page du site web de PROMISE pour faire votre demande via le formulaire dédié.